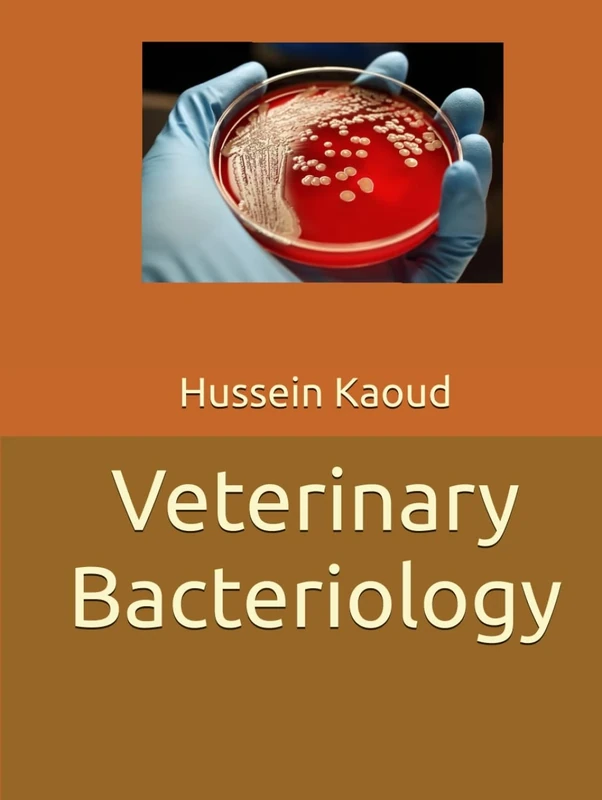
Veterinary Bacteriology

We can't find the internet
Attempting to reconnect
Something went wrong!
Hang in there while we get back on track

£59.99
Cabi Biosecurity in Animal Production and Veterinary Medicine: From principles to practice
Price data last checked 139 day(s) ago - refreshing...
We'll watch every seller, every day. One email when your price arrives.
This is the usual price. Wait for it to drop, or tell us your number.
£60 today · usual range £0–£0 · best ever £56
NEW HERE?
Amazon shows you one price. We show you all of them.
Tosheroon watches Amazon prices so you don't have to. Every product on Amazon has a price history — we make it visible. Set the price you'd actually pay, and we'll email you the second it gets there. No app, no account, one email.
WHAT'S ON THIS PAGE
when this has been cheap or pricey
where the price is heading next
all-time high & low, recent range
name your number, we'll email you
Price History & Forecast
Grey patches = out of stock. Cheaper = lower on the chart. Hover for exact prices.
Last 592 days • 592 data points (No recent data available)
Price Distribution
Price distribution over 592 days • 4 price levels
Price Analysis
Most common price: £56 (287 days, 48.5%)
Price range: £56 - £60
Price levels: 4 different prices over 592 days
Description
Key Features
New Store Stock
Product Specifications
- Brand
- Cabi
- Format
- hardcover
- ASIN
- 1789245680
- Domain
- Amazon UK
- Release Date
- 02 January 2020
- Listed Since
- 22 October 2019
Barcode
No barcode data available
Similar Products You Might Like

Biosecurity in animal production and veterinary medicine: From principles to practice
Acco

Biosecurity for Livestock Diseases in Europe: Transmission, Risk Factors, and Modelling
Cabi

Biosecurity: Understanding, Assessing, and Preventing the Threat
Wiley

Applied Biosecurity: Global Health, Biodefense, and Developing Technologies (Advanced Sciences and Technologies for Security Applications)
Springer

Springer - Confronting Emerging Zoonoses: One Health Paradigm
Springer

Infectious Diseases of the Dog and Cat
Saunders

Laboratory Biosecurity Handbook
CRC Press

Veterinary Infection Prevention and Control
Wiley

Safety Analysis of Foods of Animal Origin
CRC Press

Safety Analysis of Foods of Animal Origin
CRC Press

Antimicrobial Therapies: Methods and Protocols: 2296 (Methods in Molecular Biology, 2296)

Dictionary of Zoo Biology and Animal Management: A Guide to the Terminology Used in Zoo Biology, Animal Welfare, Wildlife Conservation and Livestock Production
Wiley-Blackwell

Harkness and Wagner's Biology and Medicine of Rabbits and Rodents
Wiley

Borrelia burgdorferi: Methods and Protocols: 1690 (Methods in Molecular Biology, 1690)
Humana

Veterinary Microbiology and Microbial Disease, 2nd Edition
Wiley-Blackwell

Wildlife Disease and Health in Conservation (Wildlife Management and Conservation)
Johns Hopkins University Press
Veterinary Bacteriology

Pathogenesis of Bacterial Infections in Animals
Wiley-Blackwell

Systems Biology, Bioinformatics and Livestock Science

Food Hygiene, Agriculture and Animal Science - Proceedings of the 2015 International Conference
World Scientific Publishing Company

Advances in Microbiology, Infectious Diseases and Public Health: Volume 1: 897 (Advances in Experimental Medicine and Biology, 897)
Springer

Viral Diseases of Cattle
Wiley-Blackwell

Host-Bacteria Interactions: Methods and Protocols: 1197 (Methods in Molecular Biology, 1197)
Humana

Saunders Comprehensive Veterinary Dictionary
Saunders Ltd.